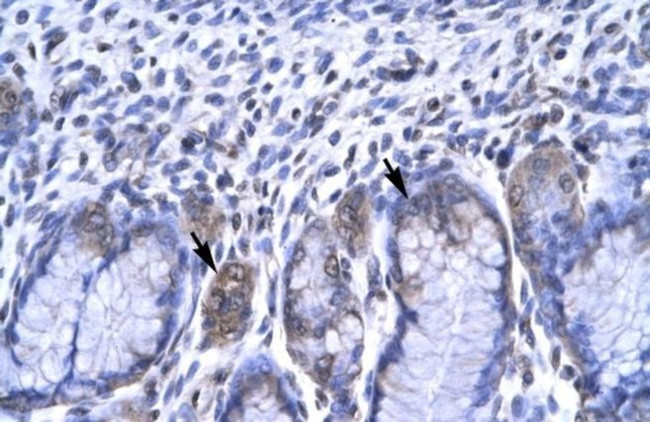
RBPJ Antibody in Immunohistochemistry (IHC)

Search
Invitrogen
RBPJ Polyclonal Antibody
{{$productOrderCtrl.translations['antibody.pdp.commerceCard.promotion.promotions']}}
{{$productOrderCtrl.translations['antibody.pdp.commerceCard.promotion.viewpromo']}}
{{$productOrderCtrl.translations['antibody.pdp.commerceCard.promotion.promocode']}}: {{promo.promoCode}} {{promo.promoTitle}} {{promo.promoDescription}}. {{$productOrderCtrl.translations['antibody.pdp.commerceCard.promotion.learnmore']}}
产品信息
PA5-40354
宿主/亚型
分类
类型
抗原
偶联物
形式
浓度
规格
保存条件
运输条件
RRID
产品详细信息
Peptide sequence: RPHCSAAGAI LRANSSQVPP NESNTNSEGS YTNASTNSTS VTSSTATVVS
Sequence homology: Cow: 100%; Dog: 100%; Guinea Pig: 100%; Horse: 100%; Human: 100%; Mouse: 93%; Rabbit: 100%; Rat: 100%
靶标信息
CSL plays a role in the regulatory network through which muscle cells coordinate their structural and functional states during growth, adaptation, and repair. The protein is abundantly expressed in heart and skeletal muscle and expression is increased by passive stretch. Mutations in this gene can lead to X-linked deafness.
仅用于科研。不用于诊断过程。未经明确授权不得转售。